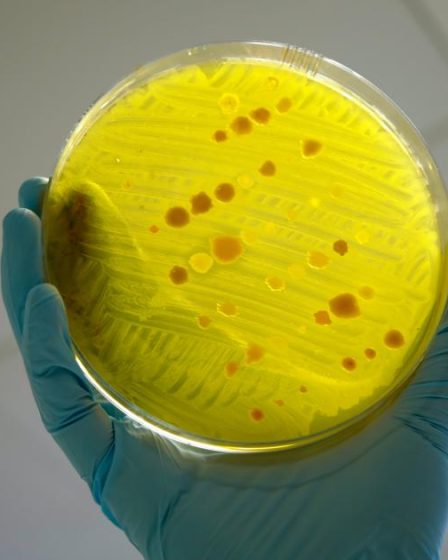
Une étude norvégienne révèle comment les eaux usées des hôpitaux propagent la résistance aux antimicrobiens 8 Une étude norvégienne révèle comment les eaux usées des hôpitaux propagent la résistance aux antimicrobiens - 7

Pour ceux qui fuient l’hiver norvégien pour une escapade au soleil, l’aéroport d’Oslo propose une astuce de voyage astucieuse pour …
Comment
Comment obtenir un passeport britannique pour un enfant né en Norvège
Bien que la citoyenneté norvégienne ne soit pas automatique pour les enfants nés en Norvège, ceux qui sont nés de …
Une étude norvégienne révèle comment les eaux usées des hôpitaux propagent la résistance aux antimicrobiens
La résistance aux antimicrobiens (RAM) survient lorsque des micro-organismes (bactéries, virus, champignons, parasites) évoluent de telle sorte qu’ils ne sont …
Comment la Norvège conquiert le marché britannique du ski
Alors que les conditions d’enneigement dans le sud de l’Europe deviennent de moins en moins prévisibles, la Norvège s’impose comme …
Comment faire de The Local l’une de vos sources préférées sur Google
Vous aimez et faites confiance à The Local ? Alors prenez un moment pour nous ajouter comme source préférée sur …
Comment Johannes Høsflot Klæbo, le vlogueur norvégien médaillé d’or, a bâti une marque valant plusieurs millions de dollars
Du jour au lendemain, la vidéo de son sprint est devenue l’un des moments les plus partagés de ces Jeux …
Comment la Norvège a transformé son pétrole en un fonds de 2 000 milliards de dollars qui pourrait ne jamais s’épuiser
Quand on pense à la Norvège, on imagine généralement des paysages enneigés, de longs hivers, des fjords, des aurores boréales …
Comment regarder les Jeux olympiques d’hiver à la télévision en Norvège
En Norvège, les sports d’hiver ne sont pas seulement un divertissement, ils constituent un rituel national. Alors que les Jeux …
Comment faire en sorte que votre amitié avec un Norvégien ne soit pas qu’une « aventure d’un soir »
Se faire des amis en Norvège est essentiel pour survivre et s’intégrer. Pourtant, les résidents étrangers découvrent souvent que naviguer …
Comment les jardins d’enfants norvégiens offrent de plus en plus de perspectives de carrière aux étrangers
Commencer une carrière en Norvège peut être difficile pour les résidents étrangers. Cependant, les jardins d’enfants deviennent un choix solide …